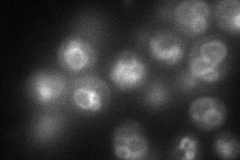
YIL047C
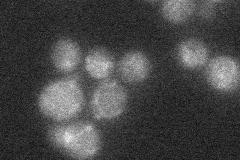
YIL047C

View description
Plasma membrane protein of unknown function; truncation and overexpression suppresses lethality of G-alpha protein deficiency
Localization:
Intensity:
Fold change:
Significance:
-
C’ GFP library in SD

vacuole membrane33.32 -
N' NOP1pr-GFP in SD
vacuole membrane69.9678 -
N' TEF2pr-mCherry in SD

vacuole membrane70.4565 -
N' NATIVEpr-GFP in SD
below threshold20.3299 -
N' TEF2pr-VC and Cyto-VN in SD

ambigous,punctate29.6105 -
C’ GFP library in SD+DTT

vacuole membrane24.770.74No -
C’ GFP library in SD+H2O2

vacuole membrane30.350.91No -
C’ GFP library in Starvation Media

vacuole membrane30.220.9No -
C’ GFP library on the background of Pup2-DaMP

vacuole membrane -
C’ GFP library on the background of CCT mutant

vacuole membrane26.46580.794096No
